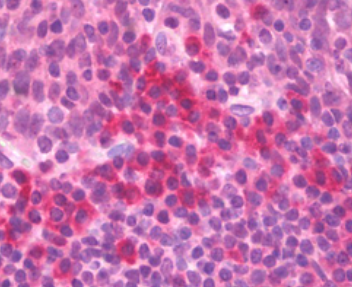
Rabbit Anti-Human TNF-α

Rabbit Anti-Human TNF-α
Rabbit Anti-Human TNF-α
询价
100ug
起订
江苏 更新日期:2026-04-05
产品详情:
- 英文名称:
- Rabbit Anti-Human TNF-α
- 产品类别:
- 抗体
公司简介
南京赛泓瑞生物长期从事elise试剂盒,omega ,sigma ,Prospec细胞因子,细胞株抗体,iNtARON分子生物学,Biomed分子生物学,蛋白分离,生化试剂,Biosera细胞培养,仪器耗材销售。公司是以实验室、医院、高校为服务对象的,提供实验的生化试剂、抗体等,销售国产和国际的产品。
| 成立日期 | (16年) |
| 注册资本 | 50.000000万 |
| 员工人数 | 10-50人 |
| 年营业额 | ¥ 500万-1000万 |
| 经营模式 | 贸易 |
| 主营行业 | 生化试剂,抗体 |
Rabbit Anti-Human TNF-α相关厂家报价
-

- Rabbit Anti-Human TNF-α
- 武汉圣洛捷生物技术有限公司
- 2026-04-05
- 询价
-

- Anti-TNF alpha:肿瘤坏死因子-α/TNFα抗体
- 上海冠导生物工程有限公司 VIP
- 2026-04-06
- 询价
-

- 人源肿瘤坏死因子-α(46-65)/144796-72-5/TNF-α (46-65) (human)
- 南京肽研生物科技有限公司 VIP
- 2026-04-05
- ¥1000
-

- 兔抗人IGG(FC)-HRP
- 北京启维益成科技有限公司
- 2026-04-05
- 询价